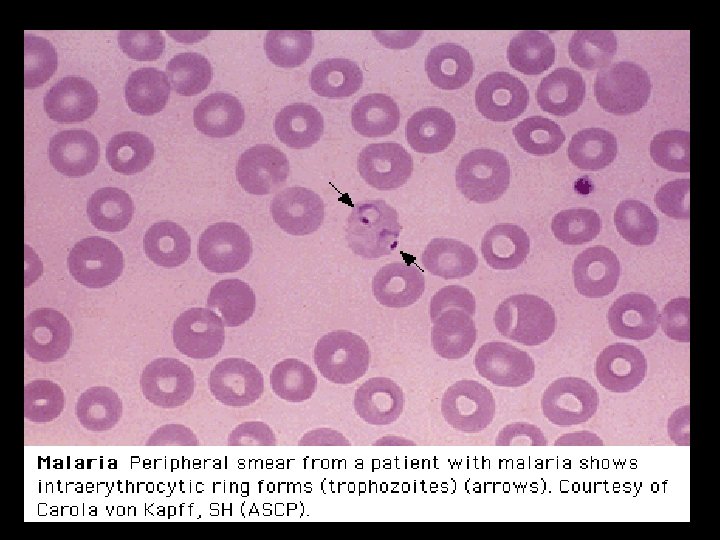
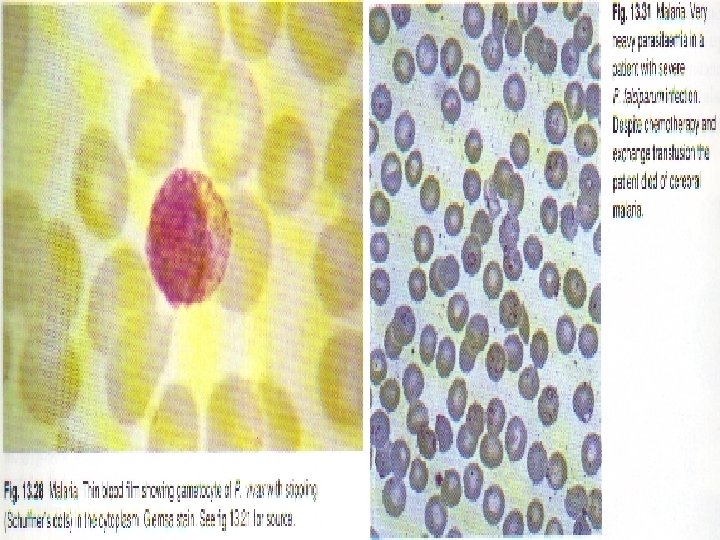

MALARIA TRAVEL MEDICINE DR AWADH ALANAZI 1435 2014

- Slides: 62
MALARIA & TRAVEL MEDICINE DR. AWADH AL-ANAZI 1435 -2014
EDUCATIONAL OBJECTIVES At the end of this lecture students are expected to know: • Epidemiology • Clinical presentation • Risk to travelers • Malaria and pregnancy • Diagnostic work up • Treatment
ETIOLOGY 4 plasmodia: · P. Falciparum · P. Vivax · P. Ovale · P. Malariae
EPIDEMIOLOGY • Endemic disease • Usually does not occur at altitudes – 1500 m • World wide ease of travel • Most important parasitic disease of humans • Transmitted in over 100 countries • Affecting more than 3 billion people world wide • Causing 1 -2 billion deaths per year
PATHOGENESIS • P. F. invades RBC at all ages - 106 2500/mcl · P. Mal: only old RBC – 10, 000/mcl • P. ovale and P. vivax invade young RBC’s. · Microvascular patholody: secondary Ischemia Adherence of • non-deformable parasitezed RBC to endothelium · Renal failure: hemalysis, Ischemia secondary microvascular pathology · Deep Coma: hypoglycemia, microvascular adherent parasitized RBC · Pulmonary edema; 2 o: Capillary leak Synd (without C. C. F. ) · Immune complex Neph. Syndrome 2 o P. Malariae
C L I N I C A L FEATURES CF vary with: • Geography • Epidemiology • Age • High risk includes ØChildren ØPregnant women ØNon-immune travelers to malarious areas
INCUBATION PERIOD • Sporozoites reach the liver within 1 -2 hours following female Anopheles mosquito bite. • Pt. asymptomatic for 12 -35 days until RBCs stage of parasite life cycle.
Life Cycle
CLINICAL FEATURES 1) Major · Recurring fevers · Chills (Assoc. RBC lysis – mature zchisonts) 2) Periodicity S/O · 48 hours: P. Vivax & Ovale · 72 hours: P. Malaria · Non-regular/hectic in P. F. especially in nonimmune Patients (who are at highest risk of complications and death)
CLINICAL FEATURES 1) Severe P. F. (> 10 parasite/ mcl): AC Complications · Renal failure · Coma 2 o: hypoglc; TNF, or microvascular pathology · Pul. Edema · Thombrocytopenia · G. Enteritis – especially diarrhea · Ch. P. Falcuparum infection • Splenomegaly – typically resolves after treatment with antimalarial meds. 6 -12 mon. · P. Malariae assoc. Immune compl. N. Synd. · P. Vivax – late splenic rupture with trauma 1 -3 mon. after initial infection
MALARIA FEVER PAROXYSMS Rigors, headache associated with pale cold skin (1 -2 hours) Delirium, Tachypnoea, Hot Skin (Several hours) Fever Marked sweating and fatigue Patient often symptoms free between paroxysms
DIAGNOSIS • Detailed targeted history including travel hx and clinical examination together with: • High Index of Suspicion (HIS)
DX: Blood film stained with · Giemsa stain or wright’s stain · Correct identification of malarial Spp is essential for treatment because of P. Falciparum R to Chloroquine · On Giemsa stain – Cytoplasm: light blue, nucleus: dark blue · In P. F (a) only ring stage a sexual parasite and gametocytes seen in periph. Blood. (b) While RBC with Trophozoites or Schixonts stage – sequestered in peripheral, Microvasculature, and NOT circulating P-blood. · All asexual erythrocytic stages of P. Vivax, Ovale & malariae circulate in peripheral blood, thus seen on Blood Smear · Acutely ill patients DDX: P. F. vs P. Vivax, because (a) P. Ovale – Vivax – clinical, morphological (b) P. malariae - ch. Infeciton
Thin blood film (RBC morphology preserved): • • P. Vivax; infected RBC enlargement with parasite maturation Scuffner’s dots (eosinophilic dots in RBC cyto. ) May see Maurer’s clots in RBC eytoplasm • • · Infection with more than one parasite spp: 5 -7% • · Thick Blood Film (RBC) lysed • • • You may examine 10 X. Blood more than in thin film More diagnostic in lower degree of parasitemias • • · Serology: not useful in managing acutely ill patient • · DNA probe: similar thick film sensitivity
Plasmodium falciparum: Blood Stage Parasites Thin Blood Smears 1: Normal red cell 2 -18: Trophozoites ( 2 -10: ring-stage trophozoites) 19 -26: Schizonts ( 26 is a ruptured schizont) 27, 28: Mature macrogametocytes (female) 29, 30: Mature microgametocytes (male) 23
Plasmodium vivax: Blood Stage Parasites Thin Blood Smears 1: Normal red cell 2 -6: Young trophozoites (ring stage parasites) 7 -18: Trophozoites 19 -27: Schizonts 28, 29: Macrogametocytes (female) 30: Microgametocyte (male) 24
Plasmodium ovale: Blood Stage Parasites Thin Blood Smears 1: Normal red cell 2 -5: Young trophozoites 6 -15: Trophozoites 16 -23: Schizonts 24: Macrogametocytes (female) 25: Microgametocyte (male) 25
Plasmodium malariae: Blood Stage Parasites Thin Blood Smears 1: Normal red cell 2 -5: Young trophozoites (rings) 6 -13: Trophozoites 14 -22: Schizonts 23: Developing gametocyte 24: Macrogametocyte (female) 25: Microgametocyte (male) 26
Differential Diagnosis of Malaria in Acutely III Patients Based on P. B. Smear P. Vivax P. Falciparum P. Ovale Multiply Infected RBC Common Rare Mature (Trophozoite and schizont) parasites Absent Common RBC enlargement with lager parasite stages Absent Common Mature (trophozoites & schizont) stage P. falciparum. Typically sequestered in the peripheral microvasculature. • RBC enlargement in P. vivax typically occurs with later stage parasites that do not circulate in P. falciparum infection.
MALARIA COMPLICATIONS Depth of coma Temp Vomiting Do not modify outcome Seizures Parasite load Anemia HIV infection did not affect clinical or biological presentation of cerebral malaria and appears not to affect outcome. (Niyongabo et al, Acta Tropica Apr 1994)
Risk factors for poor prognosis in cerebral malaria o Creatinine o Bilirubin o Lactates
MALARIA COMPLICATIONS Major clinical features of malaria are those of the complications. Majority of complications (apart from anemia) associated with P. Falciparum)
MALARIA COMPLICATIONS Majority of complications (apart from anemia) associated with P. falciparum * • • • Anemia: presents in most severe infections and parallels parasitaemia Hemolysis of infected RBC Delayed retics. release from BM Immune – mediated hemolysis of non-infected RBC
MALARIA COMPLICATIONS Majority of complications (apart from anemia) associated with P. falciparum Non-immune: (primary infection) Haemoglobinuria Black water fever • Exaggerated haemolytic response to quinine – sensitized RBC • •
MALARIA COMPLICATIONS Majority of complications (apart from anemia) associated with P. falciparum Mild unconjugated jaundice common, and parallels hemolysis. Hepatocellular dysfunction may contribute to jaundice.
MALARIA COMPLICATIONS Majority of complications (apart from anemia) associated with P. falciparum. Tissue hypoxia related complications Hypoxia results from altered microcirculation + anemia. Maturation of erythyrocyte schizonts in P. falciparum takes place in tissue capillaries and venules. P. falciparum parasitized RBC sequestered in micro circulation because: Altered deformability of parasitized RBC Adhesion involving parasite – derived proteins within RBC and glycoproteins on vascular endothelium.
Cerebral malaria à Most severe common complication Renal Failure à à à Most severe common complication ATN Dehydration Hypotension Hypervescosity Pulmonary Edema à ARDS – may complicate acute phase of severe malaise. Fluid overload may contribute.
Hypoglycemia à à à Glucose consumption Lactic acidosis Quinine/quinidine --- insulin secretion Bleeding à Thrombocytopenia Consumption coagulopathy Shock: Endotoxemia Diarrhea Hyponatremia (? SIADH)
LATE COMPLICATION • Tropical splenomegaly in P. Falciparum endemic areas. • N. syndrome with P. malariae. • Burkett’s lymphoma (PF - EBV)
MALARIA & PREGNANCY à à à à Mortality Anemia, hypoglycemia, pulmonary edema: > common Abortion Stillbirth Premature delivery high infant mortality LB wt. Placental insufficiency High parasitaemia - ? placenta favorable site for P. falciparum.
CONGENITAL MALARIA • Transplacental infection • Can be all 4 species • Commonly P. v. and P. f. in endemic areas • P. m. infections in nonendemic areas due to long persistence of species • Neonate can be diagnosed with parasitemia within 7 days of birth or longer if no other risk factors for malaria (mosquito exposure, blood transfusion) • Fever, irritability, feeding problems, anemia, hepatosplenomegaly, and jaundice • Be mindful of this problem even if mother has not been in malarious area for years before delivery
MALARIA AND HEMOGLOBINOPATHIES • Heterozygous sickle cell train children less likely to contract P. falciparum • C. S. disease: no such protection, rather mortality is higher > normal • Thalassemics: partially protected (? Fetal Hb) • G-6 -phosphatase RBC : less prone to P. falciparum.
Principles of Treatment should be guided by three main factors (CDC): • The infecting Plasmodium species • The clinical status of the patient • The drug susceptibility of the infecting parasites as determined by the geographic area where the infection was acquired and the previous use of antimalarial medicines
• If treatment must be initiated before the species is known treat as P. falciparum • P falciparum should be presumed to be chloroquine resistant, except in a few areas of Central America and the Middle East • Primaquine should be given if Plasmodium vivax or Plasmodium ovale is likely
RESISTANCE PATTERNS -Chloroquine-resistant P falciparum: Eastern Hemisphere: All of sub-Saharan Africa, Saudi Arabia, Yemen, Iran, Pakistan, Afghanistan, China, Nepal, and all of Southeast Asia Western Hemisphere: Panama, Haiti, Brazil, Peru, Bolivia, Colombia, Venezuela, Ecuador, French Guiana, Guyana, and Suriname -Chloroquine-sensitive P falciparum: Eastern Hemisphere: Turkey, Iraq, Syria, Georgia, Azerbaijan, Tajikistan, Turkmenistan, and Kyrgyzstan Western Hemisphere: Argentina, Paraguay, Mexico, Guatemala, Costa Rica, Honduras, Nicaragua, El Salvador, and Dominican Republic -Mefloquine-resistant P falciparum: Southeast Asia: Regions of Vietnam, Laos, Thailand, Burma, and Cambodia -Chloroquine-resistant P vivax: Papua New Guinea and Indonesia
TREATMENT Uncomplicated P falciparum infection : • • Artemether-Iumefantrine or, Atovaquone-proguanil or, Quinine or, Mefloquine. • Uncomplicated Plasmodium malariae, Plasmodium knowlesi, or chloroquine-sensitive P falciparum infection: • Chloroquine phosphate or, • Hydroxychloroquine. • Uncomplicated P vivax or P ovale infection, expected to be chloroquine-susceptible: • Chloroquine phosphate or, • Hydroxychloroquine.
Uncomplicated P vivax infection, expected to be chloroquine-resistant: • • Quinine or, Atovaquone-proguanil or, Mefloquine or, Amodiaquine.
COMPLICATED MALARIA • Quinidine gluconate 10 mg/kg loading dose over 1 -2 h, then 1. 2 mg/kg/h for at least 24 h • Once parasitemia is < 1% and patient can take oral medication, switch to quinine 650 mg PO TID to complete 3 -d course (7 -d course if malaria was acquired in southern Asia) • In addition, give doxycycline 100 mg IV or PO BID for 7 d. • for pregnant women, instead of doxycycline, give clindamycin 20 mg base/kg/day PO divided TID for 7 d
CHEMOPROPHYLAXIS • • • Atovaquone-proguanil, or Chloroquine phosphate, or Doxycycline, or Mefloquine or, Primaquine.
Other Measures in Treating Severe Malaria 1) Antibodies against TNF - they but no effect on mortality & morbidity ? reason fever • Effects of other cytokines as IL – 1, TNF- • On pathogenesis of complicated severe malaria
Other Measures in Treating Severe Malaria 2) Steroids - Harmful by controlled trials - Dexamethasone longer duration of coma + worse outcomes than patient receiving quinine alone (NEWJ 1982, Warrel et al) 3) Reducing mosquito – human contact 4) Malaria vaccine
Additional Supportive Measures · Blood Tx / Exchange Tx · Hypoglycemia treatment and prophylaxis especially in pregnant women. · Avoidance of IVF overload · Dialysis · Heparin for consumption coagulation · Pregnant woman should receive prophylaxis · Non-immune travellers
FUTURE PERSPECTIVE · Success to control or eradicate malaria faced by obstacles: Increasing drug resistance in P. falciparum and appearing ( R ) in P. vivax o Basis of protection against infection and disease not understood. o Biologic basis of vector capacity responsible for mosquito-borne malaria transmission is unknown. o Increasing anopheline mosquito resistance to insecticide. o
THANK YOU